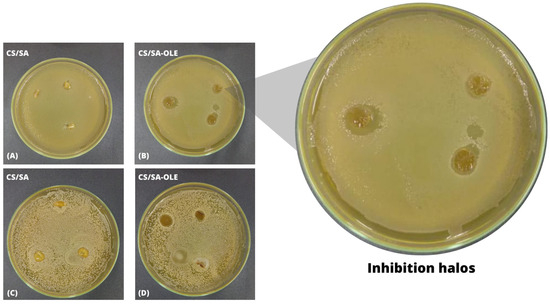

Abstract
This study seeks to enhance bilayer membranes using a combination of chitosan and sodium alginate (CS/SA) with phytochemical compounds extracted from olive leaves (CS/SA-OLE), intended for use as a skin dressing. Olive leaf extracts (OLE) were sustainably obtained and showed a phenolic composition of 114.49 mgGAE·g−1 and antioxidant activity of 94.25%. CS/AS and CS/SA-OLE were prepared using the casting method. The results showed that the addition of OLE improved the mechanical and barrier properties of the membranes. The elongation at break increased from 9.99 to 14.68%, and the water transmission rate reduced from 2207.78 to 2094.33 (g·m−2·24 h−1) after the addition of OLE. The FTIR spectra showed functional groups of phenolic compounds, and the thermogravimetric analysis showed that the addition of OLE improved the thermal stability of the membranes. In addition, the CS/SA-OLE membranes showed active potential with inhibition halos (12.19 mm) against the microorganism Escherichia coli. The membranes generated in this research, particularly those with the addition of natural extracts, exhibit significant promise for utilization as wound dressings.
1. Introduction
Skin is the outermost body layer, in continuous contact with the environment, and is highly prone to structural damage capable of limiting its protective barrier [1,2]. In general, the healing process involves several complex and dynamic events. However, bacterial colonization and subsequent infections are currently some of the factors responsible for complications in the healing process [2,3,4]. In this sense, several studies have expanded the possibilities of formulating dressings using biomaterials that favor a biological and effective response in the healing process. In general, membranes obtained from natural polymers have been explored as alternatives for the treatment of skin wounds due to their ability to stimulate the immune system, form granular tissue, promote antimicrobial protection and fibroblast migration, and good selectivity and biocompatibility, besides being natural biomolecules that reduce environmental pollution [5,6,7]. Thus, an optimal wound dressing used for physiological skin reconstruction must meet some requirements, such as absorbing excess exudate, keeping the wound moist, and being non-toxic, as well as having barrier properties, high porosity, flexibility, and mechanisms that facilitate treatment and tissue recovery more quickly and efficiently [8,9,10].
In this context, using two or more combined polymers has shown multiple favorable characteristics for their application as skin dressings due to the possibility of developing biocompatible surfaces without changing the functionality of each material [8,11]. Thus, the combination of sodium alginate and chitosan has been prominent in studies for the development of membranes due to increased mechanical stability, absorption capacity, and a suitable wetting medium for the healing process, in addition to the characteristics present in their structures, such as biocompatibility, biodegradability, barrier properties, non-immunogenicity, and non-toxicity [12,13,14,15].
According to studies, using eco-friendly agents in polymeric matrices has promoted the development of bioactive surfaces (antioxidant and antimicrobial) capable of effectively accelerating the recovery of skin integrity. [16]. In addition, applying natural extracts has been encouraged as an alternative to reduce the increasing threat of antibiotic resistance and toxicity [17]. Among the natural sources of bioactive compounds, olive leaves (Olea europaea L.) stand out because they are industrial by-products of olive growing, an important activity in the southern region of Rio Grande do Sul, Brazil. In addition, it is known that the olive pruning and harvesting stages generate a large number of olive leaves with a composition rich in phytochemicals, which have been widely used in the formulation of dressings to improve antimicrobial properties due to their effectiveness against Gram-positive (Staphylococcus aureus) and Gram-negative bacteria (Escherichia coli) [18,19,20,21]. The phenolic compounds in olive leaf extract (OLE) composition, such as oleuropein, hydroxytyrosol, and tyrosol, promote antimicrobial activities [22,23,24]. Furthermore, oleuropein is noteworthy as the main compound responsible for several pharmacological activities, such as hypotensive, antioxidant, hypoglycemic, hypocholesterolemic, antitumor, radioprotective, and anti-inflammatory effects [18,19,22,23,24,25,26], which allow an improvement in biological behavior when applied to dressing materials.
Thus, this work aims to recover the bioactive compounds in olive leaves, proposing their sustainable use as natural actives in chitosan and sodium alginate bilayer membranes for potential application in treating cutaneous wounds. The produced membranes are evaluated according to their thickness, mechanical properties, fluid drainage capacity (FDC), water vapor transmission rate (WVTR), and antimicrobial activity using thermogravimetric analysis (TGA), Fourier transform infrared spectroscopy (ATR-FTIR), and scanning electron microscopy (SEM).
2. Materials and Methods
2.1. Sample Preparation
Olive leaves (Olea europaea L., Arbequina) were collected at Estância Guarda Velha, located in Pinheiro Machado, Rio Grande do Sul (31°30′04.0″ S, 53°30′42.0″ W). After being harvested, the leaves were submitted to a sanitization process. First, the samples were washed in running water; subjected to a commercial solution of sodium hypochlorite, 2% to 2.5% (v/v), for 5 min; and finally, washed with distilled water. Then, they were dried in an oven at 40 °C for 24 h, following the methodology proposed by Martiny et al. [27]. The dried samples were ground in an analytical mill (IKA, A11, Darmstadt, Germany), and standardized using a 60-mesh sieve, manufactured to ABNT/ASTM/TYLER standard (Bertel Indùstria Mertalùrgica Ltda., Caieiras, Brazil), to obtain a particle diameter smaller than 0.272 mm.
2.2. Preparation of the Extracts
Olive leaf extracts (OLE) were obtained using a dynamic maceration process, following the methodology described by Martiny et al. [27]. In this method, 1 g of OLE was added to 50 mL of distilled water and placed in a Dubnoff metabolic bath (QUIMIS, Diadema, Brazil) for 2 h at 88 °C under constant stirring. After that, the extracts obtained were filtered under vacuum using Whatman 4 filter paper (Fisher Scientific, Hampton, VA, USA), with a diameter of 125 mm, for subsequent characterization and incorporation in the biopolymeric solution. All tests were performed in triplicate.
2.3. Characterization of Olive Leaf Extracts (OLE)
The OLE were characterized for total phenolic compounds (TPC) using the spectrophotometric method described by Singleton and Rossi [28]. The TPC characterization was performed in triplicate, quantified using a gallic acid standard curve, and expressed as milligrams of gallic acid equivalent per gram of dry matter (mgGAE·g−1 b·s). The OLEs’ antioxidant activity (AA) was also evaluated using the method developed by Brand-Williams, Cuvelier, and Berset [29]. Thus, AA evaluation was performed using a 1,1-diphenyl-2-picrylhydrazyl (DPPH) reagent and quantified using Equation (1).
where AA (%) is the antioxidant activity, Ab is the absorbance of the blank, and Aa is the absorbance of the OLE.
2.4. Synthesis of the Bilayer Membranes
The bilayer membranes CS/SA and CS/SA-OLE were obtained by adapting the methodology described by Wang et al. [11], and Figure 1 summarizes the process.

Figure 1.
Scheme for obtaining CS/SA and CS/SA-OLE membranes.
The first layer was composed of chitosan (CS) (molecular weight of 150 kDa, deacetylation degree of 85%, and particle size of 72 μm) and produced using the polymer ratio of 1:100 (m/v) with acetic acid 1% (v/v) as the solvent. The solutions were rested for 24 h and then subjected to constant stirring (193 rpm) for 15 min until a homogeneous mixture was formed. They were then dried in an oven at 40 °C for 7 h until a consistent surface was formed. The second layer was obtained by adding sodium alginate (AS) in a 1:100 (m/v) ratio in distilled water at room temperature. The solutions were subjected to constant stirring (193 rpm) for 1 h until a homogeneous mixture was formed. They were then poured over the first layer and taken to the oven for 12 h to obtain the CS/SA membranes.
The bilayer membranes (CS/SA-OLE) were obtained using the same methodology; however, part of the water that was used to solubilize the sodium alginate was substituted with the liquid extract. Thus, sodium alginate solutions (second layer of the membrane) were prepared by dissolving the polymer in 75 mL of aqueous olive leaf extract and 25 mL of distilled water.
2.5. Characterization of Membranes
The thickness of the membranes was determined using a digital micrometer (Insize-IP65, São Paulo, Brazi) at ten random positions over the area of the membranes.
The mechanical properties, tensile strength, and elongation at break of the membranes were evaluated using a texturometer (STABLE MICRO SYSTEM—TA.XT.plus, Surrey, UK) with a 50 N load cell, following the standard [30]. The distance of the grips was 50 mm with a speed of 50 mm·min−1. The analyses were performed in triplicate at room temperature and determined using Equations (2) and (3):
where T represents the tensile strength (MPa), Fm is the maximum force measured at membrane rupture (N), Amin is the minimum cross-sectional area of the membrane (m2), E (%) is the elongation at break, dr is the distance at rupture traveled by the movable grips (cm), and di is the initial distance between the grips (cm).
Fluid drainage capacity (FDC) and water vapor transmission rate (WVTR) analyses were carried out following the BS EN 13726-1 method [31], where the membranes (CS/SA and CS/SA-OLE) were cut into disks of a 2.7 cm diameter and weighed and attached to the ends of modified Paddington cups containing 20 mL of simulated body fluid (SBF). The tubes were weighed and inverted so that the samples came in contact with the SBF. The samples were then incubated in an oven in desiccators containing silica gel for 24 h at 37 °C. The water vapor transmission rate (WVTR) and fluid drainage capacity (FDC) were determined using Equations (4) and (5), respectively.
where mis is the initial mass of the system, mfs is the final mass of the system after the drainage period, mim is the initial mass of the membrane, mfm is the final mass of the membrane after the drainage period, A is the contact area between the membrane and the fluid, and t is the time.
The thermal stability of the membranes was evaluated through thermogravimetric analysis (TGA) using a thermogravimetric instrument (SHIMADZU TGA 50, Kyoto, Japan). For this assay, approximately 5 mg of the membrane samples were heated in platinum capsules over a range from 30 °C to 900 °C and at a heating rate of 10 °C·min−1 with a nitrogen flow rate of 50 mL·min−1.
The functional groups in the bilayer membranes were investigated using the Fourier transform infrared spectroscopy (ATR-FTIR) technique (SHIMADZU, Prestige 21, Nakagyo-ku, Kyoto, Japan) in a range from 400 cm−1 to 4000 cm−1 and a resolution of 4 cm−1.
The membranes were evaluated for morphology by applying gold films to the previously prepared samples and were analyzed using scanning electron microscopy (SEM) at 500 and 1000× magnifications (EVO MA10, Carl Zeiss, Jena, Germany).
2.6. Antimicrobial Activity
The bilayer membranes, with and without OLE, were studied for their microbial inhibition potential using the disk diffusion method [32]. The test was performed using an inoculated Tryptic Soy Agar (TSA) medium, where microorganisms were prepared in nutrient broths and incubated at 35 °C for 24 h. The sterilized agar plates were inoculated evenly with 105 CFU/cm2 of the microorganisms Escherichia coli (Gram-negative, ATCC 11229) and Staphylococcus aureus (Gram-positive, ATCC 12598). After that, the samples, which were cut into disks (7.5 mm) and previously sterilized under ultraviolet light (15 min for each side of the bilayer sample), were placed in contact with the contaminated Mueller–Hinton agar, and the plates were incubated at 37 °C for 24 h. After the incubation, the zone of inhibition (inhibition halos) formed by the samples for each microorganism tested was determined.
2.7. Statistical Analysis
The results were presented as mean ± standard deviation and statistically analyzed using a t-test with a 95% significance level using the STATISTICA Ultimate Academic software, version 10.0 (Starsoft Inc., Naperville, IL, USA).
3. Results and Discussion
3.1. Characteristics of Bioactive Compounds from Olive Leaves
The results obtained from the total phenolic compounds (TPC) and antioxidant activity (AA) analyses were 114.49 mgGAE·g−1 (b·s) and 94.25%, respectively. Lamprou et al. [33] obtained a TPC content of 86.4 mgGAE·g−1 for the OLE, Koroneiki variety extract, using water and 6.4% sulfuric acid (w/w) as the extracting solvent. Martiny et al. [21], using dynamic maceration and water as the extracting solvent, obtained a TPC content of 115.96 mgGAE·g−1, and Valério Filho et al. [18] obtained a TPC content of 41.64 mgGAE·g−1 for the OLE, cultivar Arbequina, using water as the extracting solvent. As for AA, the results found in this study (94.25%) were close to those reported in the literature by Moudache et al. [34], who, after 2 h of extraction, obtained an AA concentration of 95.4% for olive leaf extract. Filho et al. [18] obtained an AA concentration of 95.23% using the solid–liquid maceration method. Rosa et al. [24] obtained an AA concentration of 90.03% for the OLE using water as the solvent and the microwave-assisted extraction method. The results of the TPC and AA analyses found in the present work were similar to those obtained by the cited authors. The differences in TPC concentration and AA may be related to the cultivar variation. According to studies presented in the literature, the geographical and climatic origins of the cultivar can significantly influence the concentration of bioactive compounds present in olive leaves, with climatic conditions near the Mediterranean being the most favorable for the highest concentration of polyphenols [35]. In addition, other factors influence the process yield, such as the extraction technique and extraction solvent [36]. Given the results of the characterization of the OLE, the high presence of oleuropein demonstrates a potential application in skin dressings due to its healing properties [37].
3.2. Characteristics of Bilayer Membranes
The CS/SA and CS/SA-OLE membranes were characterized concerning their thickness, tensile strength, elongation at break, fluid drainage capacity, and water transmission rate, and the results are presented in Table 1.

Table 1.
Characterization of membranes.
According to Table 1, the results obtained for the thickness were 0.14 mm for the CS/SA and 0.22 mm for the CS/SA-OLE membranes. It was found that the addition of OLE caused a significant increase in this value. This observed effect occurred due to the linear increase in mass of the film-forming solution with the addition of the extract [19]. This effect was also reported by Arieta et al. [36], who obtained thicknesses of 0.055 mm and 0.063 mm for low-density polyethylene and cellulose acetate bilayer membranes without and with Cucumis metuliferus extract, respectively. Avila et al. [38] obtained a thickness of 0.50 mm for chitosan and zein bilayer films with 3% jaboticaba (Plinia cauliflora) peel extract. Da Rosa et al. [39] also reported an increase in the thickness of films with different concentrations of olive leaf extract. The thickness values reported in this work are close to those described in the literature and smaller than the human dermis, which ranges between 0.5 and 2.0 mm depending on factors such as age, sex, and body part [40], and this is a desirable characteristic for the applicability of a skin patch.
The CS/SA membranes exhibited a tensile strength of 4.214 MPa and an elongation at a break of 9.990%. However, the tensile strength of the bilayer membranes decreased after incorporating the OLE. In the present work, the CS/SA-EFO bilayer membranes exhibited a slightly higher elongation at break (14.686%) compared to the CS/SA membranes, although without significant differences, probably due to the presence of lipid components that acted as plasticizers in the active membranes [19]. Mouro et al. [17] evaluated the mechanical properties of polycaprolactone, poly(vinyl alcohol), and chitosan-tripolyphosphate membranes with and without Centella asiatica (L.) extract and reported a reduction in the tension and elongation of the membranes from 3.96 MPa to 3.03 MPa and 10.39% to 8.31%, respectively. In general, the parameters for applying the skin dressing will depend on the body region where the material will be inserted. Thus, the values obtained in the present study were close to those exhibited by human skin, which presents elongation between 10% and 115% and tensile strength between 2.5 and 30 MPa [41], demonstrating that the material can provide less damaging mechanical conditions at the lesion site [42,43].
The FDC values found in the present study were 1959.93 g·m−2·h−1 and 2083.47 g·m−2·24 h−1 for the membranes without (CS/SA) and with (CS/SA-OLE) the addition of the extract, respectively. The addition of OLE resulted in a high FDC; this increase may be associated with the oleuropein present in the extract, which improved the hydrophilic properties of the membranes. Genevro [44] obtained a maximum permeation of 3530.8 g·m−2·24 h−1 in konjac glucomannan membranes. Analyzing the results obtained in the literature, it was possible to observe that the permeation values presented in this study would not support the high volume of exudates (between 3400 and 5100 g·m−2·24 h−1) generated during the healing process of injuries such as third-degree burns [45]. However, the FDC results are applicable for less severe injuries such as first-degree burns, (278.4 g·m−2·24 h−1) [42,43,44]. The moisture in the wound region must be controlled to achieve optimal healing rates. Thus, the FDC is an important factor in developing skin dressings, as it is a parameter capable of preventing the accumulation of exudates and excessive dehydration of the lesion [41].
The water vapor transmission rate (WVTR) is a parameter for monitoring the ideal oxygenation capacity of a skin dressing for the healing process to occur, and according to studies, the range should be between 2000 and 2500 g·m−2·24 h−1 [17,46]. In this sense, the values obtained in the present study (2207.28 and 2094.33 g·m−2·24 h−1 for CS/SA and CS/SA-OLE, respectively) are within the ideal oxygenation range for application in skin dressings. Surendranath et al. [47] developed a zein/PEO membrane for wound healing and obtained a WVTR in the range of 1500–2000 g·m−2·24 h−1. Mouro et al. [17] developed bilayer membranes with and without natural extract (Centella asiatica L.) and analyzed the WVTR of the material, obtaining rates of 1162.94 g·m−2·24 h−1 and 1757.12 g·m−2·24 h−1 for the membranes with and without extract, respectively. According to Garcia-Orue et al. [48], the WVTR of commercial dressings is between 426 and 2047 g·m−2·24 h−1. Thus, the membranes tested in this study have the potential for application as dressings, as they are within the applicability range of commercial dressings.
The TGA and differential thermal analysis (DTA) curves of the bilayer membranes with (green line) and without (red line) OLE are shown in Figure 2.

Figure 2.
Thermogravimetric curves of the bilayer membranes without and with the addition of olive leaf extract.
The thermogravimetric analysis (TGA) curves show that the CS/SA membranes decomposed similarly to the CS/SA-OLE membranes. Based on the results, a constant weight loss was observed in the temperature range of 80–800 °C. Thus, the mass loss peaks between 100 and 190 °C can be attributed to the evaporation of water, volatile components, and glycerol [49,50]. The peak at 220 °C (third peak) can be related to the degradation of the sodium alginate polymer chains [51]. Zhang et al. [52] reported sodium alginate degradation at 235 °C and 246 °C, respectively. The fourth peak of mass loss was observed between 250 and 300 °C, which was related to the dehydration of saccharide rings, depolymerization, and the decomposition of acetylated units of the chitosan [53]. The degradation rate of both materials decreased after 400 °C. The fifth mass loss peak of the membranes (CS/SA and CS/SA-OLE) was found near 580 °C and 600 °C, which represents the residual mass values from the incomplete degradation of the inorganic compounds present in each polymer and the degradation rate of olive leaf extract [54]. Erdogan, Demir, and Bayraktar [55] observed non-degraded mass at 600 °C, estimating that degradation would be complete at temperatures above 800 °C. The CS/SA membranes were fully degraded after 800 °C, whereas the CS/SA-OLE membranes showed that 5% to 10% of their mass was not degraded [55].
The ATR-FTIR analysis of the membranes without extract (CS/SA) and with extract (CS/SA-OLE) is presented in Figure 3.

Figure 3.
ATR-FTIR analysis of the chitosan and sodium alginate bilayer membranes, both pure (CS/SA) and with olive leaf extract (CS/SA-OLE).
The ATR-FTIR spectra studied showed bands between 3000 and 3500 cm−1 in both materials (CS/SA and CS/SA-OLE), which were related to the O-H stretching vibrations of the hydroxyl groups present in polysaccharides, such as chitosan and sodium alginate, as well as water [56,57]. In addition, a broadening of this peak was observed for the CS/SA-OLE samples compared to the CS/SA samples, possibly due to compounds present in the extract, such as oleuropein [35]. The bands around 2800 and 3000 cm−1 were assigned to C-H stretching [58], being more pronounced in the CS/SA-OLE membrane spectrum due to the additional groups in the extract. Other vibration bands characteristic of polymers were observed in the CS/SA and CS/SA-OLE spectra, such as the carboxylate group, with an asymmetric stretch observed at 1600 cm−1 and a symmetric stretch at around 1420 cm−1, as well as a C-O stretch vibration represented at 1030 cm−1 [9]. The peaks observed in the present study are similar to those found by other authors in chitosan and sodium alginate-based materials [8,9,56]. In addition, the peaks obtained from the CS/SA showed a negligible shift between them, which can be explained by the electrostatic interactions between the various functional groups present in the chitosan and sodium alginate membranes, mainly through hydrogen bonds, which caused the overlapping of the spectra [59,60].
The SEM images of the CS/SA and CS/SA-OLE membranes are shown in Figure 4. In the SEM images of the membrane surface, both samples showed homogeneous surfaces. The images showed a compact structure without separation of the layers, and the good adhesion of the polymers to the membranes with the extract (CS/SA-OLE) was more visible, suggesting that the morphology of each material was preserved.

Figure 4.
SEM images of the cross-sections of the CS/SA and CS/SA-OLE bilayer membranes: (A,B) at 500×; (C,D) at 1000×.
3.3. Antimicrobial Potential of Bilayer Membranes
Figure 5 illustrates the analysis of the microbial potential of the bilayer membranes against Escherichia coli (E. coli) and Staphylococcus aureus (S. aureus). Table 2 presents the values for the inhibition halos.
Figure 5.
Microbial analysis against strains: (A,B) E. coli; (C,D) S. aureus.

Table 2.
Diameters of the inhibition zone.
Table 2 shows that CS/SA-OLE showed inhibition halos against the microorganism E. coli, indicating the presence of antimicrobial activity in the membranes with the natural extract. However, the pure membranes (CS/SA) did not show an inhibition zone for either of the two strains studied (Escherichia coli and Staphylococcus aureus). Bayraktar [61] also observed the absence of inhibition in his silk fibroin nanofibers without olive leaf extract for the studied species (Staphylococcus epidermidis and Escherichia coli) in his work. Similarly, Avila et al. [38] verified inhibition halos of 8.77 ± 0.31 mm for E. coli and 9.32 ± 0.21 mm for S. aureus in chitosan and zein fiber bilayer films with added jaboticaba peel extract, whereas the films without extract showed no inhibition against the microorganisms evaluated. Luciano et al. [62] developed bilayer gelatin films incorporated with pitanga leaf hydroethanolic extract and obtained an inhibition zone of 6.9 mm against the S. aureus microorganism.
The inhibition ability of CS/SA-OLE can be attributed to the high concentration of polyphenols, with an emphasis on oleuropein, present in the OLE obtained in this study [63]. Thus, the inhibition tests showed the potential application of CS/SA-OLE membranes as skin dressings.
4. Conclusions
The research findings revealed an abundance of total polyphenols and high antioxidant activity within the olive leaf extracts (OLE), indicating a potential source of bioactive compounds. These results reinforce the potential for recovering bioactive compounds from agricultural waste for use as a natural additive. This approach offers advantages such as cost-effectiveness due to being a by-product of olive cultivation. The characterization of chitosan and sodium alginate bilayer membranes showed good flexibility, ease of manipulation, and excellent adhesion between the layers. The inclusion of OLE significantly improved the material properties, such as the fluid drainage capacity and water vapor transmission rate. The addition of OLE reduced the tensile strength and resulted in a slight change in elongation at the break of the material. The membranes enriched with OLE exhibited remarkable features, including inhibition zones against the E. coli microorganism. Therefore, this study presented encouraging results for applying membranes as cutaneous dressings. However, further comprehensive studies, including in vivo testing, are required to validate this potential.
Author Contributions
Conceptualization, L.G.S.P. and L.B.A.; methodology, L.G.S.P. and L.B.A.; formal analysis, L.G.S.P.; investigation, L.G.S.P.; resources, L.G.S.P.; data curation, L.G.S.P.; writing—original draft preparation, L.G.S.P., L.B.A., C.C.M., G.L.D. and G.S.d.R. (Glaydson Simões dos Reis); writing—review and editing, L.G.S.P., L.B.A., C.C.M., G.L.D. and G.S.d.R. (Glaydson Simões dos Reis); visualization, L.G.S.P., L.B.A., S.M., G.S.d.R. (Gabriela Silveira da Rosa), C.C.M., M.R.K., G.L.D. and G.S.d.R. (Gabriela Silveira da Rosa); supervision, G.S.d.R. (Gabriela Silveira da Rosa). All authors have read and agreed to the published version of the manuscript.
Funding
This research was funded by the Coordination for the Improvement of Higher Education Personnel (CAPES) (PGCI88887.125421/2016-001), the Research Support Foundation of the State of Rio Grande do Sul (FAPERGS), the National Council for Scientific and Technological Development (CNPq), the Federal University of Pampa (UNIPAMPA), and the Federal University of Santa Maria (UFSM).
Institutional Review Board Statement
Not applicable.
Data Availability Statement
Not applicable.
Acknowledgments
The authors thank the Research Support Foundation of the State of Rio Grande do Sul (FAPERGS), the Federal University of Pampa and National Council for Scientific and Technological Development (CNPq). The authors thank the Research Supporting Project for funding this work through the Research Supporting Project number (RSPD2023R708), King Saud University, Riyadh, Saudi Arabia. dos Reis thanks Bio4Energy—a Strategic Research Environment appointed by the Swedish government and the Swedish University of Agricultural Sciences—for the funding support.
Conflicts of Interest
The authors declare no conflict of interest.
References
- Tamer, T.M.; Sabet, M.M.; Omer, A.M.; Abbas, E.; Eid, A.I.; Mohy-Eldin, M.S.; Hassan, M.A. Hemostatic and antibacterial PVA/Kaolin composite sponges loaded with penicillin–streptomycin for wound dressing applications. Sci. Rep. 2021, 11, 3428. [Google Scholar] [CrossRef]
- Xue, M.; Zhao, R.; Lin, H.; Jackson, C. Delivery systems of current biologicals for the treatment of chronic cutaneous wounds and severe burns. Adv. Drug Deliv. Rev. 2018, 129, 219–241. [Google Scholar] [CrossRef]
- Alminderej, F.M. Study of new cellulosic dressing with enhanced antibacterial performance grafted with a biopolymer of chitosan and myrrh polysaccharide extract. Arab. J. Chem. 2020, 13, 3672–3681. [Google Scholar] [CrossRef]
- Yin, J.; Xu, L. Batch preparation of electrospun polycaprolactone/chitosan/aloe vera blended nanofiber membranes for novel wound dressing. Int. J. Biol. Macromol. 2020, 160, 352–363. [Google Scholar] [CrossRef]
- Hassan, M.A.; Tamer, T.M.; Valachová, K.; Omer, A.M.; El-Shafeey, M.; Mohy Eldin, M.S.; Šoltés, L. Antioxidant and antibacterial polyelectrolyte wound dressing based on chitosan/hyaluronan/phosphatidylcholine dihydroquercetin. Int. J. Biol. Macromol. 2021, 166, 18–31. [Google Scholar] [CrossRef]
- Zhao, X.; Guo, B.; Wu, H.; Liang, Y.; Ma, P.X. Injectable antibacterial conductive nanocomposite cryogels with rapid shape recovery for noncompressible hemorrhage and wound healing. Nat. Commun. 2018, 9, 2784. [Google Scholar] [CrossRef]
- Fang, H.; Wang, J.; Li, L.; Xu, L.; Wu, Y.; Wang, Y.; Fei, X.; Tian, J.; Li, Y. A novel high-strength poly(ionic liquid)/PVA hydrogel dressing for antibacterial applications. Chem. Eng. J. 2019, 365, 153–164. [Google Scholar] [CrossRef]
- de Espíndola Sobczyk, A.; Luchese, C.L.; Faccin, D.J.L.; Tessaro, I.C. Influence of replacing oregano essential oil by ground oregano leaves on chitosan/alginate-based dressings properties. Int. J. Biol. Macromol. 2021, 181, 51–59. [Google Scholar] [CrossRef] [PubMed]
- Zhu, J.; Wu, H.; Sun, Q. Preparation of crosslinked active bilayer film based on chitosan and alginate for regulating ascorbate-glutathione cycle of postharvest cherry tomato (Lycopersicon esculentum). Int. J. Biol. Macromol. 2019, 130, 584–594. [Google Scholar] [CrossRef] [PubMed]
- Kamel, N.A.; Abd El-messieh, S.L.; Saleh, N.M. Chitosan/banana peel powder nanocomposites for wound dressing application: Preparation and characterization. Mater. Sci. Eng. C 2017, 72, 543–550. [Google Scholar] [CrossRef]
- Wang, L.; Wang, W.; Liao, J.; Wang, F.; Jiang, J.; Cao, C.; Li, S. Novel bilayer wound dressing composed of SIS membrane with SIS cryogel enhanced wound healing process. Mater. Sci. Eng. C 2018, 85, 162–169. [Google Scholar] [CrossRef]
- Varaprasad, K.; Jayaramudu, T.; Kanikireddy, V.; Toro, C.; Sadiku, E.R. Alginate-based composite materials for wound dressing application: A mini review. Carbohydr. Polym. 2020, 236, 116025. [Google Scholar] [CrossRef]
- Alavi, M.; Nokhodchi, A. An overview on antimicrobial and wound healing properties of ZnO nanobiofilms, hydrogels, and bionanocomposites based on cellulose, chitosan, and alginate polymers. Carbohydr. Polym. 2020, 217, 115349. [Google Scholar] [CrossRef] [PubMed]
- Zhang, M.; Qiao, X.; Han, W.; Jiang, T.; Liu, F.; Zhao, X. Alginate-chitosan oligosaccharide-ZnO composite hydrogel for accelerating wound healing. Carbohydr. Polym. 2021, 266, 118100. [Google Scholar] [CrossRef] [PubMed]
- Panawes, S.; Ekabutr, P.; Niamlang, P.; Pavasant, P.; Chuysinuan, P.; Supaphol, P. Antimicrobial mangosteen extract infused alginate-coated gauze wound dressing. J. Drug Deliv. Sci. Technol. 2017, 41, 182–190. [Google Scholar] [CrossRef]
- Abbas, M.; Arshad, M.; Rafique, M.K.; Altalhi, A.A.; Saleh, D.I.; Ayub, M.A.; Sharif, S.; Riaz, M.; Alshawwa, S.Z.; Masood, N.; et al. Chitosan-polyvinyl alcohol membranes with improved antibacterial properties contained Calotropis procera extract as a robust wound healing agent. Arab. J. Chem. 2022, 15, 103766. [Google Scholar] [CrossRef]
- Mouro, C.; Fangueiro, R.; Gouveia, I.C. Preparation and Characterization of Electrospun Double-layered Nanocomposites Membranes as a Carrier for Centella asiatica (L.). Polymers 2020, 12, 2653. [Google Scholar] [CrossRef] [PubMed]
- Valério Filho, A.; Avila, L.B.; Lacorte, D.H.; Martiny, T.R.; Rosseto, V.; Moraes, C.C.; Dotto, G.L.; Carreno, N.L.V.; da Rosa, G.S. Brazilian Agroindustrial Wastes as a Potential Resource of Bioative Compounds and Their Antimicrobial and Antioxidant Activities. Molecules 2022, 27, 6876. [Google Scholar] [CrossRef]
- Medina, E.; Romero, C.; García, P.; Brenes, M. Characterization of bioactive compounds in commercial olive leaf extracts, and olive leaves and their infusions. Food Funct. 2019, 10, 4716–4724. [Google Scholar] [CrossRef]
- Kiritsakis, K.; Goula, A.M.; Adamopoulos, K.G.; Gerasopoulos, D. Valorization of Olive Leaves: Spray Drying of Olive Leaf Extract. Waste Biomass Valorization 2018, 9, 619–633. [Google Scholar] [CrossRef]
- Şahin, S.; Bilgin, M. Olive tree (Olea europaea L.) leaf as a waste by-product of table olive and olive oil industry: A review. J. Sci. Food Agric. 2018, 98, 1271–1279. [Google Scholar] [CrossRef] [PubMed]
- Martiny, T.R.; Raghavan, V.; Moraes, C.C.d.; Rosa, G.S.d.; Dotto, G.L. Bio-Based Active Packaging: Carrageenan Film with Olive Leaf Extract for Lamb Meat Preservation. Foods 2020, 9, 1759. [Google Scholar] [CrossRef] [PubMed]
- Yahfoufi, N.; Alsadi, N.; Jambi, M.; Matar, C. The Immunomodulatory and Anti-Inflammatory Role of Polyphenols. Nutrients 2018, 10, 1618. [Google Scholar] [CrossRef] [PubMed]
- da Rosa, G.S.; Vanga, S.K.; Gariepy, Y.; Raghavan, V. Comparison of microwave, ultrasonic and conventional techniques for extraction of bioactive compounds from olive leaves (Olea europaea L.). Innov. Food Sci. Emerg. Technol. 2019, 58, 102234. [Google Scholar] [CrossRef]
- Ashkanani, M.; Farhadi, B.; Ghanbarzadeh, E.; Akbari, H. Study on the protective effect of hydroalcoholic Olive Leaf extract (oleuropein) on the testis and sperm parameters in adult male NMRI mice exposed to Mancozeb. Gene Rep. 2020, 21, 100870. [Google Scholar] [CrossRef]
- Alcaide-Hidalgo, J.M.; Margalef, M.; Bravo, F.I.; Muguerza, B.; López-Huertas, E. Virgin olive oil (unfiltered) extract contains peptides and possesses ACE inhibitory and antihypertensive activity*. Clin. Nutr. 2020, 39, 1242–1249. [Google Scholar] [CrossRef] [PubMed]
- Martiny, T.R.; Raghavan, V.; de Moraes, C.C.; da Rosa, G.S.; Dotto, G.L. Optimization of green extraction for the recovery of bioactive compounds from Brazilian olive crops and evaluation of its potential as a natural preservative. J. Environ. Chem. Eng. 2021, 9, 105130. [Google Scholar] [CrossRef]
- Singleton, V.L.; Rossi, J.A. Colorimetry of total phenolics with phosphomolybdic-phosphotungstic acid reagents. Am. J. Enol. Vitic. 1965, 16, 144–158. [Google Scholar] [CrossRef]
- Brand-Williams, W.; Cuvelier, M.E.; Berset, C. Use of a free radical method to evaluate antioxidant activity. LWT-Food Sci. Technol. 1995, 28, 25–30. [Google Scholar] [CrossRef]
- ASTM D882–12; Standard Test Method for Tensile Properties of Thin Plastic Sheeting. American Society for Testing and Materials: West Conshohocken, PA, USA, 2012.
- BS EN 13726-1:2002; Test Methods for Primary Wound Dressings. Part 1: Aspects of Absorbency, Section 3.3 Fluid Handling Capacity. British Standards Institute—BSI: London, UK, 2002.
- M02A11; Clinical and Laboratory Standards Institute Performance Standards for Antimicrobial Disk Susceptibility Tests. Clinical and Laboratory Standards Institute: Wayne, PA, USA, 2012.
- Lamprou, G.K.; Vlysidis, A.; Tzathas, K.; Vlyssides, A.G. Statistical optimization and kinetic analysis of the extraction of phenolic compounds from olive leaves. J. Chem. Technol. Biotechnol. 2019, 95, 457–465. [Google Scholar] [CrossRef]
- Moudache, M.; Colon, M.; Nerín, C.; Zaidi, F. Phenolic content and antioxidant activity of olive by-products and antioxidant film containing olive leaf extract. Food Chem. 2016, 212, 521–527. [Google Scholar] [CrossRef] [PubMed]
- Martiny, T.R.; Pacheco, B.S.; Pereira, C.M.P.; Mansilla, A.; Astorga-España, M.S.; Dotto, G.L.; Moraes, C.C.; Rosa, G.S. A Novel Biodegradable Film Based on κ-Carrageenan Activated with Olive Leaves Extract. Food Sci. Nutr. 2020, 8, 3147–3156. [Google Scholar] [CrossRef] [PubMed]
- Arrieta, M.P.; Garrido, L.; Faba, S.; Guarda, A.; Galotto, M.J.; López de Dicastillo, C. Cucumis metuliferus Fruit Extract Loaded Acetate Cellulose Coatings for Antioxidant Active Packaging. Polymers 2020, 12, 1248. [Google Scholar] [CrossRef] [PubMed]
- Samancıoğlu, S.; Esen, A.; Ercan, G.; Mansoub, N.H.; Vatansever, S.; İnce, İ. A new dressing material in diabetic wounds: Wound healing activity of oleuropein-rich olive leaf extract in diabetic rats. Gaziantep Med. J. 2016, 1, 14–21. [Google Scholar] [CrossRef]
- Avila, L.B.; Pinto, D.; Silva, L.F.O.; de Farias, B.S.; Moraes, C.C.; Da Rosa, G.S.; Dotto, G.L. Antimicrobial Bilayer Film Based on Chitosan/Electrospun Zein Fiber Loaded with Jaboticaba Peel Extract for Food Packaging Applications. Polymers 2022, 14, 5457. [Google Scholar] [CrossRef] [PubMed]
- Da Rosa, G.S.; Vanga, S.K.; Gariepy, Y.; Raghavan, V. Development of Biodegradable Films with Improved Antioxidant Properties Based on the Addition of Carrageenan Containing Olive Leaf Extract for Food Packaging Applications. J. Polym. Environ. 2020, 28, 123–130. [Google Scholar] [CrossRef]
- Lee, Y.; Hwang, K. Skin thickness of Korean adults. Surg. Radiol. Anat. 2002, 24, 183–189. [Google Scholar] [CrossRef]
- Dos Santos, D.M.; Leite, I.S.; Bukzem, A.d.L.; de Oliveira Santos, R.P.; Frollini, E.; Inada, N.M.; Campana-Filho, S.P. Nanostructured electrospun nonwovens of poly(ε-caprolactone)/quaternized chitosan for potential biomedical applications. Carbohydr. Polym. 2018, 186, 110–121. [Google Scholar] [CrossRef]
- Rahmani, H.; Najafi, S.H.M.; Ashori, A.; Fashapoyeh, M.A.; Mohseni, F.A.; Torkaman, S. Preparation of chitosan-based composites with urethane cross linkage and evaluation of their properties for using as wound healing dressing. Carbohydr. Polym. 2019, 230, 115606. [Google Scholar] [CrossRef]
- Fougeron, N.; Connesson, N.; Chagnon, G.; Alonso, T.; Pasquinet, L.; Bahuon, M.; Guillin, E.; Perrier, A.; Payan, Y. New pressure ulcers dressings to alleviate human soft tissues: A finite element study. J. Tissue Viability 2022, 31, 506–513. [Google Scholar] [CrossRef]
- Genevro, G.M.; Gomes Neto, R.J.; Paulo, L.d.A.; Lopes, P.S.; de Moraes, M.A.; Beppu, M.M. Glucomannan asymmetric membranes for wound dressing. J. Mater. Res. 2019, 34, 481–489. [Google Scholar] [CrossRef]
- Kimura, V.T.; Miyasato, C.S.; Genesi, B.P.; Lopes, P.S.; Yoshida, C.M.P.; da Silva, C.F. The effect of andiroba oil and chitosan concentration on the physical properties of chitosan emulsion film. Polímeros 2016, 26, 168–175. [Google Scholar] [CrossRef]
- Pilehvar-Soltanahmadi, Y.; Dadashpour, M.; Mohajeri, A.; Fattahi, A.; Sheervalilou, R.; Zarghami, N. An Overview on Application of Natural Substances Incorporated with Electrospun Nanofibrous Scaffolds to Development of Innovative Wound Dressings. Mini Rev. Med. Chem. 2018, 18, 414–427. [Google Scholar] [CrossRef] [PubMed]
- Surendranath, M.; Rajalekshmi, R.; Ramesan, R.M.; Nair, P.; Parameswaran, R. UV-Crosslinked Electrospun Zein/PEO Fibroporous Membranes for Wound Dressing. ACS Appl. Bio Mater. 2022, 5, 1538–1551. [Google Scholar] [CrossRef]
- Garcia-Orue, I.; Santos-Vizcaino, E.; Etxabide, A.; Uranga, J.; Bayat, A.; Guerrero, P.; Igartua, M.; de la Caba, K.; Hernandez, R.M. Development of Bioinspired Gelatin and Gelatin/Chitosan Bilayer Hydrofilms for Wound Healing. Pharmaceutics 2019, 11, 314. [Google Scholar] [CrossRef]
- Chu, Y.; Xu, T.; Gao, C.; Liu, X.; Zhang, N.; Feng, X.; Tang, X. Evaluations of physicochemical and biological properties of pullulan-based films incorporated with cinnamon essential oil and Tween 80. Int. J. Biol. Macromol. 2019, 122, 388–394. [Google Scholar] [CrossRef]
- Dou, B.; Dupont, V.; Williams, P.T.; Chen, H.; Ding, Y. Thermogravimetric kinetics of crude glycerol. Bioresour. Technol. 2009, 100, 2613–2620. [Google Scholar] [CrossRef]
- Li, K.; Zhu, J.; Guan, G.; Wu, H. Preparation of chitosan-sodium alginate films through layer-by-layer assembly and ferulic acid crosslinking: Film properties, characterization, and formation mechanism. Int. J. Biol. Macromol. 2018, 122, 485–492. [Google Scholar] [CrossRef]
- Zhang, W.; Shu, C.; Chen, Q.; Cao, J.; Jiang, W. The multi-layer film system improved the release and retention properties of cinnamon essential oil and its application as coating in inhibition to penicillium expansion of apple fruit. Food Chem. 2019, 299, 125109. [Google Scholar] [CrossRef]
- Poonguzhali, R.; Basha, S.K.; Kumari, V.S. Synthesis and characterization of chitosan-PVP-nanocellulose composites for in-vitro wound dressing application. Int. J. Biol. Macromol. 2017, 105, 111–120. [Google Scholar] [CrossRef]
- Khalil, M.M.H.; Ismail, E.H.; El-Magdoub, F. Biosynthesis of Au nanoparticles using olive leaf extract. Arab. J. Chem. 2012, 5, 431–437. [Google Scholar] [CrossRef]
- Erdogan, I.; Demir, M.; Bayraktar, O. Olive leaf extract as a crosslinking agent for the preparation of electrospun zein fibers. J. Appl. Polym. Sci. 2015, 132. [Google Scholar] [CrossRef]
- Kiti, K.; Suwantong, O. Bilayer wound dressing based on sodium alginate incorporated with curcumin-β-cyclodextrin inclusion complex/chitosan hydrogel. Int. J. Biol. Macromol. 2020, 164, 4113–4124. [Google Scholar] [CrossRef] [PubMed]
- Chang, C.; Duan, B.; Cai, J.; Zhang, L. Superabsorbent hydrogels based on cellulose for smart swelling and controllable delivery. Eur. Polym. J. 2010, 46, 92–100. [Google Scholar] [CrossRef]
- Ren, H.; Gao, Z.; Wu, D.; Jiang, J.; Sun, Y.; Luo, C. Efficient Pb(II) removal using sodium alginate-carboxymethyl cellulose gel beads: Preparation, characterization, and adsorption mechanism. Carbohydr. Polym. 2016, 137, 402–409. [Google Scholar] [CrossRef]
- Kubovský, I.; Kačíková, D.; Kačík, F. Structural Changes of Oak Wood Main Components Caused by Thermal Modification. Polymers 2020, 12, 485. [Google Scholar] [CrossRef]
- Kuila, S.B.; Ray, S.K. Separation of benzene–cyclohexane mixtures by filled blend membranes of carboxymethyl cellulose and sodium alginate. Sep. Purif. Technol. 2014, 123, 45–52. [Google Scholar] [CrossRef]
- Bayraktar, O. Silk fibroin nanofibers loaded with hydroxytyrosol from hydrolysis of oleuropein in olive leaf extract. Text. Leather Rev. 2018, 1, 90–98. [Google Scholar] [CrossRef]
- Luciano, C.G.; Rodrigues, M.M.; Lourenço, R.V.; Bittante, A.M.Q.B.; Fernandes, A.M.; do Amaral Sobral, P.J. Bi-layer Gelatin Film: Activating Film by Incorporation of “Pitanga” Leaf Hydroethanolic Extract and/or Nisin in the Second Layer. Food Bioprocess Technol. 2021, 14, 106–119. [Google Scholar] [CrossRef]
- De la Ossa, J.G.; Fusco, A.; Azimi, B.; Esposito Salsano, J.; Digiacomo, M.; Coltelli, M.-B.; De Clerck, K.; Roy, I.; Macchia, M.; Lazzeri, A.; et al. Immunomodulatory Activity of Electrospun Polyhydroxyalkanoate Fiber Scaffolds Incorporating Olive Leaf Extract. Appl. Sci. 2021, 11, 4006. [Google Scholar] [CrossRef]
Disclaimer/Publisher’s Note: The statements, opinions and data contained in all publications are solely those of the individual author(s) and contributor(s) and not of MDPI and/or the editor(s). MDPI and/or the editor(s) disclaim responsibility for any injury to people or property resulting from any ideas, methods, instructions or products referred to in the content. |
© 2023 by the authors. Licensee MDPI, Basel, Switzerland. This article is an open access article distributed under the terms and conditions of the Creative Commons Attribution (CC BY) license (https://creativecommons.org/licenses/by/4.0/).





